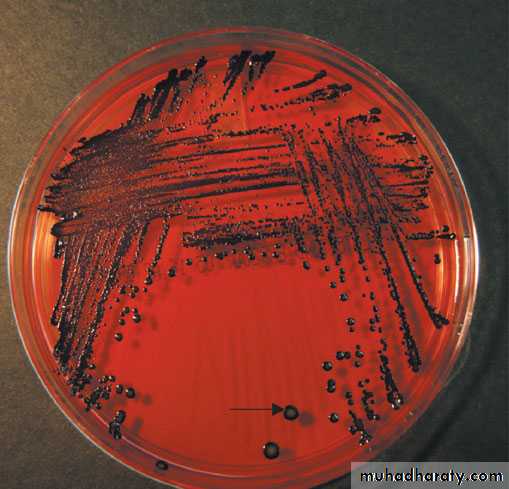

ANAEROBIC BACTERIA
Introduction:Anaerobes are characterized by their ability to grow only in an atmosphere containing less than 20% oxygen (i.e., they grow poorly if at all in room air.)
TABLE 1-1 Anaerobic Bacteria of Medical Interest:
Morphology Gram Stain GenusSpore-forming rods + Clostridium – None Non–spore-formingrods+ Actinomyces, Bifidobacterium, Eubacterium, Lactobacillus,Propionibacterium– Bacteroides, FusobacteriumNon–spore-formingcocci+ Peptococcus,Peptostreptococcus,Streptococcus– Veillonella
Clinical Infections
Many of the medically important anaerobes are part of the normal human flora.Diseases caused by members of the anaerobic normal flora are characterized by abscesses which are most frequently , located in the brain, lungs, female genital tract, biliary tract,and other intra-abdominal sites .*Most abscesses contain more than one organism, either multiple anaerobes or amixture of anaerobes plus facultative anaerobes. It is thought that the facultative anaerobes consume sufficient oxygen to allow the anaerobes to flourish
Three important findings on physical examination that arouse suspicion of an anaerobic infection are:
1-A foul-smelling ,2-discharge, 3-gas in the tissue, and necrotic tissue.
**** In addition,
infections in the setting of pulmonary aspiration,
bowel surgery, abortion, cancer, or human and animal bites frequently involve anaerobes.
Two aspects of microbiologic diagnosis of an anaerobic infection are important even before the specimen is cultured: (1)obtaining the appropriate specimen and (2) rapidly transporting the specimen under anaerobic conditions to the laboratory.
**An appropriate specimen is one that does not contain members of the normal flora to confuse the interpretation. For example,such specimens as blood, pleural fluid, pus, and transtracheal aspirates are appropriate, but sputum and feces are not.
In the laboratory, the cultures are handled and incubated under anaerobic conditions. In addition to the usual diagnostic criteria of Gram stain, morphology, and biochemical reactions, the special technique of gas chromatography is important. In this procedure, organic acids such as formic, acetic, and propionic acids are measured.
Treatment
In general, surgical drainage of the abscess plus administration of antimicrobial drugs are indicated. Drugs commonly used to treat anaerobic infections are penicillin G, cefoxitin, chloramphenicol,clindamycin, and metronidazole. Note, however,that many isolates of the important pathogen B. fragilis produce α-lactamase and are thus resistant to penicillin .
CLOSTRIDIUM** *
There are four medically important species: Clostridium tetani, Clostridium botulinum, Clostridium perfringens (which causes either gas gangrene or food poisoning), and Clostridium difficile . All clostridia are anaerobic, spore-forming, gram positive rods
1. Clostridium tetani
Disease
Clo. tetani causes tetanus.
Transmission
Spores are widespread in soil. The portal of entry is usually a wound site (e.g., where a nail penetrates the foot), but the spores can also be introduced during “skin-popping,” atechnique used by drug addicts to inject drugs into the
skin.
Germination of spores is favored by necrotic tissue and poor blood supply in the wound. Neonatal tetanus, in which the organism enters through a contaminated umbilicus or circumcision wound, is a major problem in some developing countries.
Pathogenesis
Tetanus toxin (tetanospasmin) is an exotoxin produced by vegetative cells at the wound site. This polypeptide toxin is carried intra-axonally (retrograde) to the central nervous system, where it binds to ganglioside receptors and blocks release of inhibitory mediators (e.g., glycine and GABA) at spinal synapses
Clinical Findings
Tetanus is characterized by strong muscle spasms (spastic paralysis, tetany). Specific clinical features include lockjaw (trismus) due to rigid contraction of the jaw muscles,which prevents the mouth from opening, a characteristic grimace known as risus sardonicus, and exaggerated reflexes..
Opisthotonos, a pronounced arching of the back
due to spasm of the strong extensor muscles of the back, is often seen. Respiratory failure ensues. A high mortality rate is associated with this disease. Note that in tetanus, spastic paralysis (strong muscle contractions) occurs, whereas in botulism, flaccid paralysis (weak or absent muscle contractions) occurs.Laboratory Diagnosis
There is no microbiologic or serologic diagnosis. Organisms are rarely isolated from the wound site. Clo. tetani produces a terminal spore (i.e., a spore at the end of the rod). This gives the organism the characteristic appearance of a “tennis racket
Treatment
Tetanus immune globulin (tetanus antitoxin) is used to neutralize the toxin. The role of antibiotics is uncertain. If antibiotics are used, either metronidazole or penicillin G can be given. An adequate airway must be maintained and respiratory support given. Benzodiazepines (e.g., diazepam[Valium]) should be given to prevent spasms.
Prevention
Tetanus is prevented by immunization with tetanus toxoid(formaldehyde-treated toxin) in childhood and every 10 years thereafter. Tetanus toxoid is usually given to children
in combination with diphtheria toxoid and the acellularpertussis vaccine (DTaP).
The administration of both immune globulins and tetanus toxoid (at different sites in the body) is an example of passive-active immunity.
2. Clostridium botulinum
Disease
Clo. botulinum causes botulism.
Transmission
Spores, widespread in soil, contaminate vegetables and meats. When these foods are canned or vacuum-packed without adequate sterilization, spores survive and germinate in the anaerobic environment.
Toxin is produced within the canned food and ingested preformed The highest-risk foods are (1) alkaline vegetables such as green beans, peppers, and mushrooms and (2) smoked fish. The toxin is relatively heat-labile; it is inactivated by boiling for several minutes. Thus, disease can be prevented by sufficient cooking.
Pathogenesis
Botulinum toxin is absorbed from the gut and carried via the blood to peripheral nervesynapses, where it blocks release of acetylcholine it is among the most toxic substances known.
There are eight immunologic types of toxin; types A, B, and E are the most common in human illness.
Botox is a commercial preparation of exotoxin A used to remove wrinkles on the face.
Minute amounts of the toxin are effective in the treatment of certain spasmodic muscle disorders such as torticollis, “writer’s cramp,” and blepharospasm.
Clinical Findings
Descending weakness and paralysis, including diplopia,dysphagia, and respiratory muscle failure, are seen. No fever is present. In contrast, Guillain-Barre syndrome is an ascending paralysis.
Two special clinical forms occur:
(1) wound botulism,in which spores contaminate a wound, germinate, and produce toxin at the site; and (2) infant botulism, in which the organisms grow in the gut and produce the toxin there.
Ingestion of honey containing the organism is implicated in transmission of infant botulism. Affected infants develop weakness or paralysis and may need respiratory support but usually recover spontaneously.
Laboratory Diagnosis
The organism is usually not cultured. Botulinum toxin is demonstrable in:
1- uneaten food and 2-the patient’s serum by mouse protection tests.( Mice are inoculated with a sample of the clinical specimen and will die unless protected by antitoxin.)
Treatment
Trivalent antitoxin (types A, B, and E) is given, along with respiratory support. The antitoxin is made in horses,and serum sickness occurs in about 15% of antiserum recipients
Prevention
Proper sterilization of all canned and vacuum-packed foods is essential. Food must be adequately cooked to inactivate the toxin. Swollen cans must be discarded (clostridial proteolytic enzymes form gas, which swells cans).
3. Clostridium perfringens
Clo. perfringens causes two distinct diseases, gas gangrene and food poisoning, depending on the route of entry into the body.
Disease: Gas Gangrene
Gas gangrene (myonecrosis, necrotizing fasciitis ) is one of the two diseases caused by Clo. Perfringens Gas gangrene is also caused by other histotoxic clostridia such as Clostridium histolyticum, Clostridium septicum,Clostridium novyi , and Clostridium sordellii . ( Clo. sordellii
also causes toxic shock syndrome in postpartum and postabortion woman.)
Transmission
Spores are located in the soil; vegetative cells are members of the normal flora of the colon and vagina. Gas gangrene is associated with war wounds, automobile and motorcycle accidents, and septic abortions (endometritis).
Pathogenesis
Organisms grow in traumatized tissue (especially muscle)and produce a variety of toxins. The most important is alpha toxin (lecithinase), which damages cell membranes,including those of erythrocytes, resulting in hemolysis.
Degradative enzymes produce gas in tissues
Gas gangrene. Note large area of necrosis on lateralaspect of foot. Necrosis mainly caused by lecithinase producedby Clostridium perfringens . Gas in tissue is a feature of gangrene producedby this anaerobic bacteria. A large gas and fluid-filled bulla isseen near the ankle. (Used with permission from David Kaplan, MD
Clinical Findings
Pain, edema, cellulitis, and gangrene (necrosis) occur in the wound area. Crepitation indicates the presence of gas in tissues. Hemolysis and jaundice are common as are blood-tinged exudates. Shock and death can ensue. Mortality rates are highLaboratory Diagnosis
Smears of tissue and exudate samples show large gram positive rods. Spores are not usually seen because they are formed primarily under nutritionally deficient conditions.The organisms are cultured anaerobically and then identified by sugar fermentation reactions and organic acid production.
Clo. perfringens colonies exhibit a double zone of hemolysis on blood agar. Egg yolk agar is used to demonstrate the presence of the lecithinase. Serologic tests are not useful.
Treatment
*Penicillin G is the antibiotic of choice.
*Wounds should be debrided.
Prevention
Wounds should be cleansed and debrided. Penicillin may be given for prophylaxis. There is no vaccine.
Disease: Food Poisoning
Food poisoning is the second disease caused by Clo.perfringens .Transmission
Spores are located in soil and can contaminate food. The heat-resistant spores survive cooking and germinate.
The organisms grow to large numbers in reheated foods,especially meat dishes
Pathogenesis
Clo. perfringens is a member of the normal flora in the colon but not in the small bowel, where the enterotoxin acts to cause diarrhea. The mode of action of the enterotoxin is the same as that of the enterotoxin of Staphylococcus aureus(i.e., it acts as a superantigen).
Clinical Findings
The disease has an 8- to 16-hour incubation period and is characterized by watery diarrhea with cramps and little vomiting. It resolves in 24 hours.
Laboratory Diagnosis
This is not usually done. There is no assay for the toxin. Large numbers of the organisms can be isolated from uneaten food.
Treatment
Symptomatic treatment is given; no antimicrobial drugs are administered.
Prevention
There are no specific preventive measures. Food should be adequately cooked to kill the organism.
Clostridium difficile
Disease
Clo. difficile causes antibiotic-associated pseudomembranous colitis . Clo. difficile is the most common nosocomial (hospital-acquired) cause of diarrhea.
Pseudomembranous colitis. Note yellowishplaque-like lesions in colon. Caused by an exotoxin produced byClostridium difficile that inhibits a signal transduction protein, leadingto death of enterocytes. (Reproduced with permission from Fauci AS et al (eds):Harrison's Principles of Internal Medicine , 17th ed. New York: McGraw-Hill, 2008,pg 1837. Copyright c 2008 by The McGraw-Hill Companies, Inc.)
Transmission
The organism is carried in the gastrointestinal tract in approximately 3% of the general population and up to 30% of hospitalized patients. Most people are not colonized,which explains why most people who take antibiotics do not get pseudomembranous colitis. It is transmitted by the fecal–oral route. The hands of hospital personnel are important intermediaries.Pathogenesis
Antibiotics suppress drug-sensitive members of the normal flora, allowing Clo. difficile to multiply and produce exotoxine .Clindamycin was the first antibiotic to be recognized as a cause of pseudomembranous colitis, but many antibioticsare known to cause this disease. At present, second- and third-generation cephalosporins are the most common causes because they are so frequently used. Ampicillin and fluoroquinolones are also commonly implicated. In addition to antibiotics, cancer chemotherapy also predisposes
to pseudo-membranous colitis. Clo. difficile rarely invades the intestinal mucosa .
Clo. difficile causes diarrhea associated with pseudomembranes (yellow-white plaques) on the colonic mucosa.
The diarrhea is usually not bloody,and neutrophils are found in the stool in about half of the cases. Fever and abdominal cramping often occur. The
pseudomembranes are visualized by sigmoidoscopy.
Toxic megacolon can occur, and surgical resection of the colon may be necessary. Pseudomembranous colitis(PMC) can be distinguished from the transient diarrhea that occurs as a side effect of many oral antibiotics by testing for the presence of the toxin in the stool.
In 2005, a new, more virulent strain of Clo. difficile
emerged. This new strain causes more severe disease, is more likely to cause recurrences, and responds less well to metronidazole than the previous strain. The strain is also characterized by resistance to quinolones. It is thought that the widespread use of quinolones for diarrheal disease may have selected for this new strain.
Laboratory Diagnosis
The presence of exotoxins in the filtrate of a patient’s stool specimen is the basis of the laboratory diagnosis.
There are two types of tests usually used to detect the exotoxins. One is an enzyme-linked immunosorbent assay
(ELISA) using known antibody to the exotoxins. The
ELISA tests are rapid but are less sensitive than the cytotoxicity test. In the cytotoxicity test, human cells in culture are exposed to the exotoxin in the stool filtrate and the death of the cells is observed. This test is more sensitive and specific
but requires 24 to 48 hours’ incubation time.
**PCR assay for the presence of the toxin gene DNA is also used.
Prevention
There are no preventive vaccines or drugs. Because antibiotics are an important predisposing factor for PMC, they should be prescribed only when necessary. The use of probiotics to prevent PMC is not recommended.
BACTEROIDES & PREVOTELLA
Diseases
Members of the genus Bacteroides are the most common cause of serious anaerobic infections (e.g., sepsis, peritonitis,
and abscesses). Bacteroides fragilis is the most frequent pathogen.
Prevotella melaninogenica is also an important pathogen.
Pre. melaninogenica was formerly known as Bacteroides melaninogenicus, and both names are still encountered.
Important Properties
Bacteroides and Prevotella organisms are anaerobic, non–spore-forming, gram-negative rods. Of the many species of Bacteroides, two are human pathogens: Bac. fragilis, 7 and Bacteroides corrodens
Members of the Bac. fragilis group are the predominant organisms in the human colon, numbering approximately 10 11 /g of feces, and are found in the vagina of approximately
60% of women. Pre. melaninogenica and Bac. Corrodens occur primarily in the oral cavity.
Pathogenesis & Epidemiology
Because Bacteroides and Prevotella species are part of the normal flora, infections are endogenous, usually arising from a break in a mucosal surface, and are not communicable.
These organisms cause a variety of infections, such as local abscesses at the site of a mucosal break, metastatic abscesses by hematogenous spread to distant organs, or lung abscesses by aspiration of oral flora Predisposing factors such as surgery, trauma, and chronic disease play an important role in pathogenesis.
Local tissue necrosis, impaired blood supply, and growth of facultative anaerobes at the site contribute to anaerobic infections. The facultative anaerobes, such as E. coli, utilize the oxygen, thereby reducing it to a level that allows the anaerobic Bacteroides and Prevotella strains to grow. As as result, many anaerobic infections contain a mixed facultative and anaerobic flora.
Clinical Findings
The Bac. fragilis group of organisms is most frequently associated with intra-abdominal infections, either peritonitis or localized abscesses. Pelvic abscesses, necrotizing fasciitis, and bacteremia occur as well.
Laboratory Diagnosis
Bacteroides species can be isolated anaerobically on blooda gar plates containing kanamycin and vancomycin to inhibit unwanted organisms. They are identified by biochemical reactions (e.g., sugar fermentations) and by production of certain organic acids (e.g., formic, acetic, and propionic acids), which are detected by gas chromatography.Pre. melaninogenica produces characteristic black colonies
Treatment
Members of the Bac. fragilis group are resistant to penicillins,first-generation cephalosporins, and aminoglycosides,making them among the most antibiotic-resistant of the anaerobic bacteria. Penicillin resistance is the result of β-lactamase production. Metronidazole is the drug of choice, with cefoxitin, clindamycin, and chloramphenicol
as alternatives.
Prevention
Prevention of Bacteroides and Prevotella infections perioperative administration of a cephalosporin, frequently cefoxitin, for abdominal or pelvic surgery. There is no vaccine.